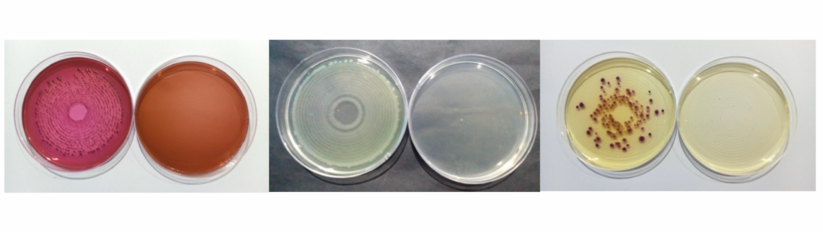
Can the Supertowel be used for water purification?

To us design means action
Supertowel™ is a reusable and highly durable towel that includes a permanently bonded anti-microbial layer.

Health, Hygiene and the importance of handwashing
Supertowel™ is a reusable and highly durable towel that includes a permanently bonded anti-microbial layer. It is designed to provide clean hands without using soap and using only a small amount of water. The materials in Supertowel consists of 80% polyester and 20% polyamide.
Handwashing is one of the most important and efficient public health interventions in the world. Every year, 1.8 million children do not live to celebrate their fifth birthday because of diarrheal diseases and pneumonia. Handwashing is among the most effective and inexpensive ways to prevent these diseases. This simple behavior can save lives, cutting diarrhea by almost one-half and acute respiratory infections by nearly one-quarter. Handwashing impacts not only health but also education, economics and equity. It plays an important role in achieving the Sustainable Development Goals - contributing to improved sanitation, zero hunger, good health, quality education, equity and much more.

Supertowel is designed with a permanently bonded antimicrobial technology. When wetted and rubbed against the hands, the pathogens will be transferred to the towel and killed. The antimicrobial technology forms a positively charged layer on the fabric. This layer will attract and kill the negatively charged microbes, like bacteria and fungi. The treatment does not contain any harmful chemicals.
Frequently Asked Questions
What is the Supertowel?add
The Supertowel is designed to be an alternative to handwashing with soap for contexts where water and soap are scarce. It is a product designed and developed by Real Relief and partners.
What are the main benefits of the Supertowel?add
Scientifically proven efficacy as handwashing tool
- Easy access to handwashing everywhere
- Does not require handwashing stations
- No soap required and only very little water
- Low cost
- Well accepted by users
Seems to improve frequency of handwashing among users
How was Supertowel Developed?add

Supertowel was developed in response to a funding call announced by the Humanitarian Innovation Fund in 2017. The call asked applicants to ‘reimagine soap’ and to make hand hygiene more feasible in humanitarian contexts. With funding from the Humanitarian Innovation Fund and USAID's Bureau for Humanitarian Assistance we have been developing and evaluating the product over the last four years. During this time, we have conducted research and design work with a range of humanitarian and academic partners including the London School of Hygiene and Tropical Medicine (LSHTM), KET’s Scientific Research Centre, Stanford University, Tufts University, Lancon Environmental, Boston University, Biotech Testing Services, the Royal College of Art, The Danish Refugee Council, Action Contre la Faim (ACF), ZOA and the British Red Cross.
How do you use Supertowel for hand cleaningadd

The Supertowel is made from a piece of microfibre cloth which has been treated with a permanent antimicrobial coating. Users ½should dip the cloth in water, wring it out, and then wipe the cloth on their hands, following similar steps to handwashing as with soap. Once damp, the Supertowel can be carried with a person and re-used multiple times throughout the day.
Does the Supertowel need soap or detergent to work?add
No. Supertowel will work without soap when used as a hand cleaning product. The Supertowel may however get visibly dirty after having been used several times. It could increase the appeal of the product and frequency of use if the Supertowel is washed at regular intervals.
How much water does Supertowel require for hand cleaning?add
Based on our laboratory studies hand washing for 15 seconds with bar soap uses approximately 760 ml of water. Handwashing for 60 seconds with the same soap consumes about 1,650 ml. The Supertowel consumes an average of 52 ml when soaked and then wrung so that it remains damp. With this water it can be used for the next 3-5 hours while damp. In settings where water is scarce, we commonly observe populations having to prioritise water for tasks other than handwashing (e.g. bathing, laundry, drinking and cooking)1,2. Being able to save this much water on a routine behaviour like handwashing can make a big difference to populations.
How should Supertowel be used outside the home?add
Since Supertowel is so mobile it can easily be taken with a person when he is leaving the house and are often particularly useful for hand cleaning in public environments where handwashing facilities are not always available. In some settings the Supertowel has been distributed in a small waterproof bag so that it can be stored while damp and outside the house. In other settings people prefer to drape the towel around their shoulders to keep them cool in hot temperatures.
Can the Supertowel be used with grey water or surface water in lakes and rivers?add
Yes. If acceptable to populations, the Supertowel can be dipped into contaminated water prior to its use for hand cleaning. The antimicrobial properties of the Supertowel will kill anything in the water leaving the Supertowel clean for handwashing. In laboratory tests we artificially contaminated water with non-pathogenic E. coli to a level (2,000 cfu/100 mL) which is double the acceptable level of contamination for handwashing3. Under these conditions both handwashing with soap and hand cleaning with the Supertowel were shown to be equally efficacious4.
How should the Supertowel be maintained?add
If Supertowel becomes visibly dirty or smelly it can be washed in clean or soapy water. The Supertowel can be cleaned with all other laundry and does not require special cleaning products or processes. We recommend soaking the towel, then gently rubbing it with soap and water, squeezing it and hanging it to dry in fresh air.
Should I dry the Supertowel after use?add
Drying is not necessary for Supertowel to be efficacious. The Supertowel will disinfect itself while wet. We recommend line drying the towel.
Will the Supertowel still work if it gets oily or muddy?add
Yes. In laboratory-based tests we artificially contaminated the Supertowel with mud and oil and found that it was as effective as a clean Supertowel4. However, when the Supertowel becomes physically dirty it could create barriers to use because it will be less desirable
How does the Supertowel remove and kill pathogens?add
The Supertowel is designed to effectively remove pathogens from hands and then kill them. It does this through two modes of action:
- The specially designed microfiber fabric is responsible for removing germs from hands and other surfaces. Microfibers are particularly efficacious at removing pathogens because they are comprised of thousands of individual fibres which increase the contact area and storage capacity of the fabric
- The antimicrobial treatment that is applied to the microfibre will kill pathogens that have been removed from the hands or surface. The antimicrobial treatment is non-toxic and is bonded to the microfibre meaning that it does not come off on someone’s hands during use. The antimicrobial treatment used on the Supertowel is not new and is used in many other applications from inhibition of smell in sportswear and apparel to prevention of biofilm creation in human implants. The antimicrobial treatment uses positively charged carbon chains which are fixed to the microfibres. Pathogens are attracted to this positive charge but upon contact the carbon chains disrupt the outer cell wall of the pathogen, thereby killing it.
Which pathogens can the Supertowel kill?add
The efficacy of the Supertowel in killing certain pathogens has been assessed according to the test standard JIS L 1902/ISO 20743, which are recognised standards for “testing the antibacterial activity and efficacy of textile products”. The test involves adding a small amount of each pathogen on Supertowel samples and evaluating the reduction occurring after 24 hours. These tests were performed on a wide range of bacteria, both gram+ and gram-, as well as fungi. Supertowel displays antimicrobial activity against all strains tested. This includes bacteria like cholera, shigella, and E. coli which are common communicable disease-causing pathogens in humanitarian contexts. For full test results see:
Experimental tests conducted by London School of Hygiene and Tropical Medicine have indicated that the Supertowel may remove and kill Chlamydia trachomatis, the pathogen which causes trachoma. Work on Chlamydia trachomatis in laboratory settings is complex and remains in its infancy. Further work related to trachoma is planned to verify these results.
Further details on the pathogen kill tests can be found in PDF summaries at:
Supertowel wash resistance. AATCC 100 - 2012
Supertowel antimicrobial efficacy after 0 and 20 washes. JIS L 1920:2015
Supertowel efficacy against different strains. JIS L 1920:2015
Preliminary studies of the efficacy of Supertowel used as a water filter
Supertowel speed of efficacy. Modified AATCC 100 – 2012
Is the Supertowel efficacious against viruses?add
In theory, the antimicrobial treatment on the Supertowel, is efficacious against incapsulated or enveloped viruses5 such as SARS CoV-2. Recent studies at Tufts University have investigated the virucidal efficacy of Supertowel after 15 min of contact time. Results are preliminary and unpublished, but it seems that the Supertowel and the other antimicrobial surface tested, are ineffective at killing SARS-CoV-2. On-going studies at Stanford University, is elaborating on the tests performed by Tufts and further investigating whether the Supertowel is indeed efficacious against SARS CoV-2 in practical application.
How long does the Supertowel last for?add
We estimate that a Supertowel will last for 12 months, but it is highly dependent on the intensity of use. This estimate is based on two studies:
- The first study is a laboratory wash test. In this test the efficacy of Supertowel is assessed when new, showing strong bactericidal efficacy – log10 reduction > 4 meaning >99,99% reduction, the Supertowel were then repeatedly machine washed. After 100 washes they found the Supertowel could still reduce bacteria by >80%6.
- The second test was a natural experiment. Action Contre la Faim distributed the Supertowels as part of hygiene kits distributed within an internal displacement camp in Northern Nigeria. A small sample of towels was collected at 3, 6 and 9 months. These were sent to a laboratory in India where pathogen kill tests were performed. This study is ongoing but initial results indicate that the towels remain efficacious at 3 and 6 months.
Replacing Supertowel after 6-12 months is likely to be necessary as by this time, they may be visually dirty or torn and this could affect the desirability and use of the product
How much time does it take to effectively clean hands with the Supertowel?add
We have performed several laboratory-based studies to assess the efficacy of the Supertowel when used for different durations. Just like handwashing with soap, the Supertowel will be more effective the longer it is used for. In general, we would recommend hand cleaning with the Supertowel for 30 seconds. When used for 60 seconds we typically see a log10 reduction in pathogens of 4.11, when used for 30 seconds we see a log10 reduction of 3.50 and when used for 15 seconds we see a log10 reduction of 2.71. These tests were based on non-pathogenic E. coli4,7.
Is the Supertowel as effective as soap?add

Our laboratory studies have shown that the Supertowel is more effective at removing non-pathogenic E. coli from the hands of volunteers than soap and water. These results are based on the European Standard (EN 1499) for testing hand cleaning products and are true when hand cleaning with soap or the Supertowel is practiced for 60 seconds or 30 seconds4,7. However, when explaining the efficacy of the product to populations we recommend that you say that the Supertowel is as effective as hand washing with soap and should be considered as an alternative when soap and water are scarce. The Supertowel is not designed to be completely replacing soap and it is important that people understand that handwashing with soap remains one of the most effective ways to reduce disease transmission.
Can the Supertowel be used for personal hygiene or cleaning surfaces?add
Yes. In fact, our research with displaced populations in Ethiopia8 and Nigeria have indicated that the multi-purpose nature of the Supertowel is seen as a key advantage by populations. In addition to hand cleaning, the Supertowel can be used to clean faces or bodies or surfaces (e.g. kitchen surfaces, or frequently touched surfaces mobile phones, doorknobs, water taps etc.). The Supertowel will use the same two mechanisms of action described above to remove and then kill pathogens on these surfaces. In studies so far, the use of the Supertowel for other types of cleaning has not prevented people from using it for handwashing.
Can the Supertowel be used for water purification?add
The Supertowel was always designed to be a hand cleaning product. However, while testing the product in a refugee camp in Ethiopia8, some of our participants asked if it might also work to treat water. Following this we conducted a preliminary laboratory test where contaminated water was poured through the Supertowel either as is or folded to allow the water to pass through two layers of Supertowel fabric. The test showed a very effective bacteria reduction in water contaminated with E. coli, P. aeruginosa and V. cholerae9. In all cases the reduction was > 99,999%, only E. coli needed the Supertowel to be folded. Further testing would be needed prior to recommending its use for water filtration.
Is the Supertowel an acceptable and feasible alternative to handwashing with soap?add
To date our research indicates that the Supertowel is generally acceptable to people of different ages, abilities, ethnicities, and religions. It is also considered to be a feasible product for use in humanitarian crises and contexts where regular handwashing is challenging to practice.
This conclusion is based on research in a refugee camp in Ethiopia, an IDP camp in Nigeria as well as increasing demand for the product in high-income settings. The study in Ethiopia8 was specifically designed to understand the acceptability of the product. We distributed 123 Supertowel, one for each member of 19 households, except babies (approx. <2 years of age). We interviewed each family three times over the course of 14 days about their experiences of using the Supertowel. At the same time, we conducted focus group discussions with people who had not received the Supertowel and in these we asked participants to rate the Supertowel and a range of locally available soap products against a range of criteria. From this research we learned that the participants:
- trusted the efficacy of the product from the outset
- ranked the Supertowel more desirable than all other soap products that were locally available.
- reported feeling that their hands were notably cleaner after using the Supertowel.
- valued the product and liked that it was distributed to each person rather than one per family.
- felt that it saved water and time because it was more convenient than handwashing with soap.
- liked that it was multi-functional (e.g. could be used for hand cleaning and cleaning in the home)
The work in Nigeria is ongoing but indicates similar levels of acceptability as in Ethiopia. For more information on the acceptability of the Supertowel read the research study8 done by the London School of Hygiene and Tropical Medicine in partnership with the Danish Refugee Council.
Does the Supertowel improve the frequency of hand cleaning?add
The studies to understand the effect of Supertowel on handwashing behaviour performed so far look promising. Below we indicate some of what we know:
- During the study in Ethiopia use of the Supertowel was measured over the course of the two weeks following distribution. Use was gauged through spot checks to see whether the Supertowel within each household were wet or damp (indicating that they had been used that day). In the first week 90% of households were actively using the Supertowel and in week two 100% of households were found to be using it. In interviews participants described being able to adapt to the new behaviour easily and quickly.
- In Nigeria handwashing behaviour is being measured over the course of nine months following the camp-wide distribution of Supertowel. Here we are using a mixture of self-reported behaviour and structured observations. Initial self-reported use appears to be high, and staff report commonly seeing people walking around the camp with their Supertowel. The results from this research will indicate how handwashing behaviour may change over time with the introduction of the Supertowel.
- In Ethiopia and Nigeria participants have reported that the Supertowel particularly makes it easier to wash hands at certain specific occasions. These include when travelling outside the household, while preparing food and while caring for children or others with special needs.
Does the Supertowel reduce the use of soap?add
Handwashing is often not a priority use of soap in settings where soap is a scarce commodity. Instead, soap is prioritized for tasks like bathing, laundry and dishes. Our research indicates that the Supertowel may help families to prioritize soap across their hygiene needs by providing an alternative way of hand cleaning. We know this based on the ongoing operational research in Nigeria. Here they distributed Supertowel to each household through routine hygiene kit distributions. In the two intervention areas, households received the Supertowel in addition to standard amounts of soap. In the control area they received only the standard amount of soap. Initial results indicate that the households in the control area ran out of soap within the first month following distribution, while the households in the intervention arm continued to have a supply of soap for other household tasks for at least three months after distribution.
Is the Supertowel intuitive to use?add

At the moment, it is not always obvious when a person first encounters the Supertowel that it is a product for hand cleaning. This became clear in focus group discussions in Ethiopia when we asked participants who knew nothing about the product to guess what it was used for and how it was supposed to be used. We showed some simple pictograms to the participants (see Figure 5) after which they understood what the Supertowel was to be used for. We have been working with the Royal College of Art to adjust the design of the Supertowel and to develop guidance on its use which can be understood even with limited literacy.
Is there any standard communications package about the Supertowel?add
Yes. We have designed a package that can be used by frontline staff (e.g. Hygiene Promoters). The package includes a fold out poster and a set of activities that are designed to be done in small groups (e.g. by bringing neighbouring households together, or gathering small groups at the distribution point).
- The fold out poster: This has diagrams of how the Supertowel works, how it can interrupt disease transmission and how the Supertowel should be used. The poster is designed to be eye-catching, interactive and has limited wording meaning that most of the content can be understood by people with limited literacy. It is available in English but can easily be translated and edited. All households receiving the Supertowel should receive the poster.
- The communications package for hygiene promoters: This provides a step-by-step guide for how to communicate about the Supertowel. It outlines a set of activities that are designed based on behaviour change principles.
The communications package was co-created with the London School of Hygiene and Tropical Medicine and the Royal College of Art. It is available free of charge in an electronic version by contacting Real Relief.
How should the Supertowel be distributed?add
We recommend that one Supertowel is given to all household members above the age of 2. The rationale behind not including children under the age of two is that children of this age typically require their parents support to clean their hands and are therefore likely to share a Supertowel. To facilitate distribution, it is necessary to have an indication of the number of people per household in advance.
Supertowel can be distributed as a separate item or as part of hygiene kits. At the point of distribution, it is essential that populations receive an explanation of the product, how it works and how to use it (e.g. through the communications package). The Supertowel is not designed to fully replace soap. Even if the Supertowel is used for most hand hygiene tasks, soap is still critical for other household tasks and hygiene behaviours.
How much does Supertowel cost?add
The nominal cost of the Supertowel is relatively easy to calculate. When procured in bulk (<20,000 pcs) and for the purposes of humanitarian use, the price of the Supertowel is 50 US$ cents. This does not include freight however, so depending on destination another 10 to 20 cents would be added before the Supertowel is on ground. The actual low procurement cost is however only a part of the cost savings that is offered by Supertowel. The savings on distribution cost is probably the bigger part. It is however almost impossible to estimate this cost on a general basis. The cost savings towards soap is best illustrated with an example:
The Sphere standards state that each person needs to access to 250 grams of soap for bathing per person per month and 200 grams of soap for laundry per person per month. They do not actually specific mention handwashing soap per person but just that soap should be provided at the handwashing station (one station per shared toilet or one per household). So, under a set of typical assumptions, in practice this would mean that the cost per household per month of providing soap for handwashing ranges between $2 and $9. In comparison the cost per Supertowel in the first month costs $2.50 per household.
Over a year of displacement and in camp of 1000 families (approx. 5000 people) this would mean handwashing soap costs would be $24,000 (based on cheapest estimate) and Supertowel costs would be $5000. This does not include distribution costs.
Reasons for choosing Supertowel™
Health and hygiene:
Cost Savings:
Supertowel™ is developed in partnership with the humanitarian sector.
Supertowel was originally presented as a proposal to the challenge #ReimagineSoap by the Humanitarian Innovation Fund (HIF).
A subsequent project was funded by the HIF, where handwashing with the Supertowel was compared in the lab to water and soap. Following a successful outcome, a user acceptance field study was conducted under the same grant in a refugee camp in Ethiopia.
A production scale-up project, where the production method for Supertowel was developed, was also funded by the HIF. The project successfully established a supply chain that can provide Supertowel at the right quality, quantity and price.
Supertowel has furthermore received funding from USAID OFDA for extended laboratory studies, where handwashing with Supertowel is compared again to handwashing with soap and water, but under more realistic conditions, i.e shorter time, less water, contaminated water source and visibly dirty.
The Supertowel™ project
The Supertowel™ project is supported by Elhra's Humanitarian Innovation Fund programme, a grant making facility supporting organisations and individuals to identify, nuture and share innovative and scalable solutions to the most pressing challenges facing effective humanitarian assistance. The HIF is funded by aid from the UK Government. Visit www.elrha.org for more information about Elrha's work to improve humanitarian outcomes through research, innovation and partnership.

Supertowel™ - re-engineering handwashing - our commitment to humanitarian innovation.
This research was made possible by the generous support of the American people thorugh the United States Agency for international development (USAID). The contents are the responsibility of the authors of the paper and do not necessarily reflect the views of USAID or the United States government.

Links to peer reviewed scientific papers:
- “Efficacy of the SuperTowel®- An Alternative Hand-washing Product for Humanitarian Emergencies” The American Journal of Tropical Medicine and Hygiene
- “Could the Supertowel be used as an alternative hand cleaning product for emergencies? An acceptability and feasibility study in a refugee camp in Ethiopia” PLOS ONE
- “Evaluating the Efficacy of the Supertowel™ as a Handwashing Product- A Simulation of Real-World Use Conditions” The American Journal of Tropical Medicine and Hygiene
